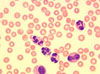

| Сайт для врачей и фармацевтов | |||||||||||||||||||||||||||||||||||||||||||||||||||||||||||||||||||||||||||||||||||||||
|
| ||||||||||||||||||||||||||||||||||||||||||||||||||||||||||||||||||||||||||||||||||||||
| Партнеры | Vox populi - vox dei |
Результаты предыдущих голосований Всегда ли вы находите ответы на ваши вопросы в Medicus Amicus? Да - 184 [75%]   Нет - 60 [24%]   Всего голосов: 245 | |
| Главная Болезни Синдромы Диагностика Лечение Образование Сотрудничество Подписка PR Зарубежье | |||
|
Medicus Amicus - это медицинский сайт, фотосайт, психологический сайт, сайт постоянного медицинского образования, медицинская газета и даже медицинский журнал. Все замечания и пожелания присылайте используя форму обратной связи Все права защищены и охраняются законом. © 2002 - 2026 Rights Management Автоматизированное извлечение информации сайта запрещено. Подробности об использовании информации, представленной на сайте в разделе "Правила использования информации" | |||
|
| |||





 У 20 здоровых добровольцев в возрасте от 19 до 30 лет (7 мужчин и 13 женщин) изучены закономерности временных колебаний значений общих..
У 20 здоровых добровольцев в возрасте от 19 до 30 лет (7 мужчин и 13 женщин) изучены закономерности временных колебаний значений общих.. Почти 15 лет минуло с выхода публикации, в которой сообщалось о существенном улучшении пространственно – временных интеллектуальных способностей у студентов колледжа после прослуши..
Почти 15 лет минуло с выхода публикации, в которой сообщалось о существенном улучшении пространственно – временных интеллектуальных способностей у студентов колледжа после прослуши.. Статья подготовлена интернет-журналом MedMir.com, «Обзоры мировых медицинских журналов на русском языке» (адрес в интернете medmir.com)..
Статья подготовлена интернет-журналом MedMir.com, «Обзоры мировых медицинских журналов на русском языке» (адрес в интернете medmir.com).. Стероид-резистентный нефротический синдром (СРНС) является одним из наиболее тяжелых состояний в нефрологии, что определяется высокой частотой развития хронической почечной недос..
Стероид-резистентный нефротический синдром (СРНС) является одним из наиболее тяжелых состояний в нефрологии, что определяется высокой частотой развития хронической почечной недос.. Прибор, недавно испытанный в США, позволяет легко захватить специфический вид иммунных клеток и аккуратно изолировать их от остальных ингредиентов крови. Исследователи и медики над..
Прибор, недавно испытанный в США, позволяет легко захватить специфический вид иммунных клеток и аккуратно изолировать их от остальных ингредиентов крови. Исследователи и медики над..
 Новости
Новости 